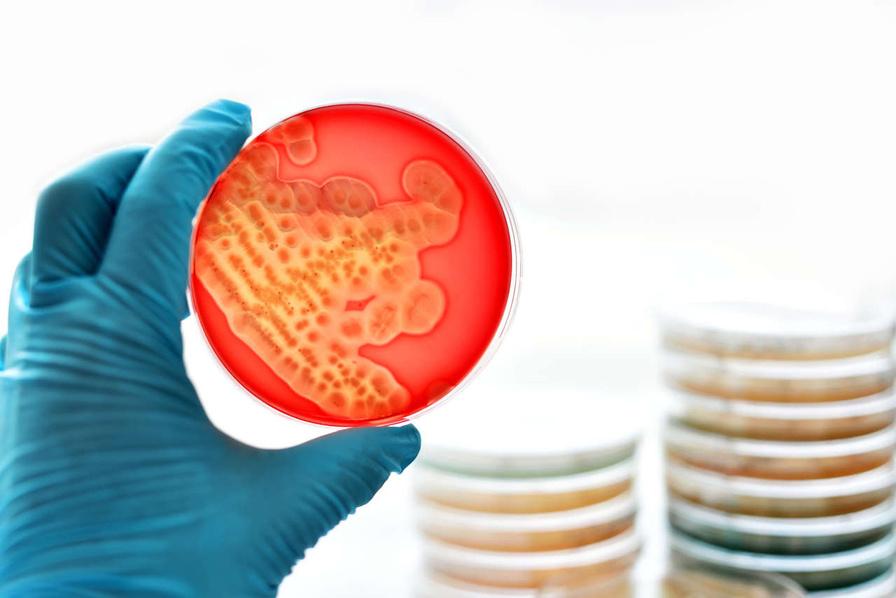

MINIÓRGANOS

EL CICLO MENSTRUAL PUEDE CAMBIAR TU CEREBRO

LA ELA

Explorando juntos las novedades científicas de la biología
01
BIOLOGICAL NEWSLETTER
EL ‘DÉJÀ VU’
ÍNDICE
PORTADA…….………………………………………………………………………….…PAG 1
ÍNDICE……….………………………………………………………………………….…..PAG 2
MINIÓRGANOS………………………………………………………………………….…PAG 3
IDENTIFICACIÓN DE 5 SUBTIPOS DE CONTUSIONES CEREBRALES CON IA……………………………………………….PAG 3
EL CICLO MENSTRUAL PUEDE CAMBIAR TU CEREBRO……………..………….PAG 4
LA ANSIEDAD CON EL ALCOHOL…………………………..……………..………….PAG 4
LA ELA…………………………..……………..…………………………………………...PAG 5
LA VITAMINA D…………………………..……………..…………………………………PAG 5
DETECCIÓN DEL CÁNCER DE MAMA………………………………………………...PAG 6
AVANCES RECIENTES EN LA LUCHA CONTRA EL CÁNCER DE MAMA………PAG 6
EL TABACO Y SUS HUELLAS…………………………………………………………..PAG 7
LA LUCHA CONTRA LAS SUPERBACTERIAS……………………..………………..PAG 7
¿TIENE EL ASMR ALGÚN BENEFICIO PSICOLÓGICO?…..……..………………..PAG 8
EL TESTIMONIO DE ‘POLIO PAUL’’……………………….…..……..………………..PAG 8
BENEFICIOS DE HACER EJERCICIO EN AYUNAS…………..……………………..PAG 8
EL ‘DÉJÀ VU’………………………………………………………..……………………..PAG 9
NUEVA INFECCIÓN BACTERIANA…………………………………………..….……..PAG 9
CONCLUSIÓN………………………..…………………………………….……..……….PAG 10
NEWSLETTER 02
BIOLOGICAL


https://elpais.com/ciencia/2024-03-04/miniorganoshumanos-creados-con-celulas-fetales-permiten-tratarenfermedades-antes-de-nacer html
IDENTIFICACIÓN DE 5 SUBTIPOS DE CONTUCIONES CEREBRALES CON IA
MINIÓRGANOS
Científicos europeos han logrado un avance notable al crear miniórganos humanos utilizando células fetales del líquido amniótico, sin afectar al feto ni a la madre Estos miniórganos, que incluyen réplicas de pulmones, intestinos y riñones, permiten diagnosticar y tratar enfermedades congénitas antes del nacimiento El estudio destaca el potencial del líquido amniótico como fuente de células madre para la medicina regenerativa, abriendo nuevas posibilidades en medicina prenatal y el desarrollo de terapias personalizadas para enfermedades raras y congénitas
Rubén Armañanzas, investigador de la Universidad de Navarra, junto con la empresa Brainscope, ha descubierto cinco tipos diferentes de lesiones cerebrales utilizando inteligencia artificial (IA) y datos de electroencefalograma (EEG) Este hallazgo tiene el potencial de mejorar la evaluación y tratamiento de las conmociones cerebrales Utilizando datos de más de 700 pacientes, la IA ayudó a identificar y mejorar la detección de estas lesiones. El objetivo principal es que estos descubrimientos lleguen a los médicos para mejorar el cuidado de los pacientes Armañanzas ha estado investigando durante años cómo la IA puede beneficiar a la medicina, creyendo que puede ayudar a predecir qué pacientes responderán mejor a ciertos tratamientos, aunque enfatiza que los médicos seguirán tomando las decisiones finales, con la IA como una herramienta de apoyo.
https://biotech-spain com/es/articles/un-investigador-de-la-universidadidentifica-cinco-subtipos-de-contusiones-cerebrales-gracias-a-lainteligencia-artificial/

03
EL CICLO MENSTRUAL PUEDE CAMBIAR TU CEREBRO
Estudios recientes muestran que el volumen o grosor de ciertas regiones del cerebro se expanden durante el ciclo menstrual, pero no revelan si eso está conectado con las fluctuaciones emocionales. Las resonancias magnéticas recientes del cerebro de mujeres muestran que el aumento y la caída de las hormonas sexuales durante el ciclo menstrual remodelan drásticamente regiones del cerebro que controlan emociones, memoria, comportamiento y la eficiencia de la transferencia de información Esto es especialmente notable dado que la mayoría de las mujeres experimentan casi 450 ciclos menstruales durante 30-40 años Los estudios combinan imágenes cerebrales y mediciones hormonales en las mismas personas, lo que proporciona una imagen más clara de cómo estas hormonas dan forma no solo a la morfología cerebral, sino también a la arquitectura funcional del cerebro.

https://www nationalgeographic com/premium /article/menstruation-brain-women-reshape

LA ANSIEDAD CON EL ALCOHOL
El alcohol interfiere con la química cerebral, disminuyendo la cantidad de sustancias calmantes y afectando el bienestar La ansiedad después de beber puede rastrearse hasta la alteración de un neurotransmisor llamado ácido gammaaminobutírico (GABA), que juega un papel clave en el sueño, la relajación y la calma del sistema nervioso central Mientras el alcohol aumenta las acciones del GABA, la cantidad de este neurotransmisor que produce el cuerpo disminuye, lo que puede resultar en ansiedad. Otro producto químico cerebral, llamado glutamato, puede aumentar aún más la ansiedad Aunque estos efectos pueden ser temporales en bebedores sociales ocasionales, en bebedores crónicos, la desregulación del sistema GABA-glutamato puede ser más pronunciada y persistente. Además, varios procesos biológicos, como la eliminación del alcohol del cuerpo y los efectos en el sueño y el azúcar en la sangre, pueden contribuir indirectamente a la ansiedad
https://www nationalgeographic com/premium/articl e/drinking-anxious-morning-after-hangover
04
LA ELA

https://www elmundo es/cienciay-
salud/salud/2022/06/15/62a9c9c afdddff150c8b45a9 html
LA VITAMINA D
La esclerosis lateral amiotrófica (ELA) es una enfermedad neurodegenerativa devastadora que afecta a las neuronas motoras, causando una progresiva pérdida del control muscular. Aunque su causa exacta sigue siendo desconocida, se cree que factores genéticos y ambientales pueden estar involucrados Los síntomas incluyen debilidad muscular, dificultad para hablar, tragar y respirar, y calambres musculares. Aunque no hay cura, ciertos medicamentos pueden aliviar los síntomas y ralentizar su avance, mientras que la fisioterapia y los dispositivos ortopédicos pueden mejorar la calidad de vida de los pacientes Además de Stephen Hawking, otros personajes famosos han sido afectados por esta enfermedad, destacando la necesidad continua de investigación para encontrar tratamientos más efectivos
https://www nationalgeographic com es/ciencia/elaenfermedad-neuronas 20533
La importancia de la vitamina D ha ganado prominencia debido a su asociación con diversas enfermedades y la posible deficiencia generalizada en la población. Aunque su obtención a través del sol y la dieta es crucial, el déficit sigue siendo alto, especialmente en ciertos grupos demográficos La suplementación puede ser necesaria para abordar este déficit, pero su exceso puede desencadenar problemas de salud graves, como la hipervitaminosis D. Por lo tanto, es fundamental ejercer precaución y basarse en la evidencia científica al considerar el uso de suplementos de vitamina D Armañanzas lleva muchos años investigando cómo la IA puede ayudar en la medicina Piensa que la IA puede predecir qué pacientes responderán bien a ciertos tratamientos, como la quimioterapia. Sin embargo, él cree que los médicos siempre tomarán las decisiones finales y que la IA solo está aquí para ayudarlos en su trabajo

https://www.nationalgeographic.com.es/ciencia/mitos-y-realidadessobre-vitamina-d-estamos-abusando-complementos 21624
https://www sportlife es/nutricion/vita mina-d-y-actividad-fisica-como-serelacionan-nzm 204351 102.html
05
DETECCIÓN DEL CÁNCER DE MAMA
El reciente avance en la detección del cáncer de mama ofrece una perspectiva emocionante en la lucha contra esta enfermedad Desarrollado por investigadores de la Universidad de Florida y la Universidad Nacional Yang Ming Chiao Tung de Taiwán, este revolucionario test de saliva promete revolucionar la detección temprana del cáncer de mama, especialmente en áreas con recursos limitados Publicado en el Journal of Vacuum Science & Technology B, el dispositivo portátil puede identificar biomarcadores específicos en muestras de saliva en menos de cinco segundos, incluso a concentraciones muy bajas, superando los métodos convencionales. Su simplicidad y tamaño compacto lo hacen accesible y fácil de usar, proporcionando resultados rápidos con solo una gota de saliva Este avance no solo mejora la detección del cáncer de mama, sino que también promete impactar positivamente la salud femenina en general, siendo una herramienta no invasiva, rápida y económica que podría implementarse ampliamente en diversos entornos médicos. En resumen, este test de saliva marca el comienzo de una nueva era en la detección del cáncer de mama, con el potencial de salvar vidas y transformar la forma en que enfrentamos esta enfermedad a nivel mundial

https://www nationalgeographic com es/cienci a/nueva-era-deteccion-cancer-mama 21622

AVANCES RECIENTES EN LA LUCHA CONTRA EL CÁNCER DE MAMA
Los avances recientes en la lucha contra el cáncer de mama son emocionantes y prometedores Aunque el cáncer de mama sigue siendo común, con 1 de cada 8 mujeres españolas en riesgo de desarrollarlo en algún momento de sus vidas, la investigación médica está mejorando las tasas de supervivencia Por ejemplo, ahora contamos con tecnologías innovadoras, como un dispositivo diseñado por el MIT que utiliza inteligencia artificial para detectar tumores mamarios en etapas tempranas, lo que facilita la autoexploración y el diagnóstico precoz. Además, los científicos han descubierto que la leche materna podría contener señales tempranas de la enfermedad, lo que podría ayudar en la detección precoz Estos avances son fundamentales porque ofrecen esperanza y muestran cómo la ciencia está trabajando para mejorar la salud de las personas
https://www nationalgeographic com es/ciencia/luc ha-contra-cancer-mama-no-se-frena-estos-hansido-ultimos-avances 20886
https://images app goo gl/wjMN4cD3u5dMNiyZ7
06
EL TABACO Y SUS HUELLAS

El tabaco ejerce un impacto profundo en la respuesta inmunitaria del cuerpo, como lo indica un estudio reciente. Incluso después de dejar de fumar, persisten alteraciones en el sistema inmunológico, lo que puede comprometer la capacidad del organismo para defenderse contra infecciones Este estado inflamatorio generado por el tabaco no solo afecta la respuesta inespecífica del sistema inmunitario, sino que también induce cambios a nivel genético que pueden aumentar el riesgo de desarrollar enfermedades como el cáncer Es esencial concienciar sobre los riesgos del tabaquismo y proporcionar apoyo para que las personas abandonen este hábito y protejan su salud a largo plazo
https://www nationalgeographic com es/ciencia/tab aco-altera-respuesta-inmunitaria-incluso-anosdespues-dejar-fumar 21611
LA LUCHA CONTRA LAS SUPERBACTERIAS
Las superbacterias constituyen una grave crisis de salud pública, con alrededor de 700,000 muertes anuales y proyecciones alarmantes que sugieren un aumento hasta los 10 millones de decesos para 2050 Sin embargo, hay una nueva luz en el horizonte: los bacteriófagos, virus especializados que pueden atacar bacterias resistentes a los antibióticos Aunque se enfrentan a desafíos, investigaciones recientes han demostrado su potencial para combatir estas infecciones, ofreciendo una esperanza renovada en la lucha contra estas peligrosas enfermedades. Con esfuerzos continuos para expandir y mejorar esta terapia viral, podemos enfrentar con mayor eficacia esta creciente amenaza para la salud mundial

https://www nationalgeographic com es/ciencia/nue va-esperanza-lucha-contra-superbacterias 21562
07
¿TIENE EL ASMR ALGÚN BENEFICIO PSICOL
Es una sensación de hormigueo cerebral que gusta solo a determinadas personas. Sus siglas corresponden con: Respuesta Sensorial Meridiana Autónoma El ASMR podría provocar una mejora en los niveles de estrés
La Universidad de Sheffield estudió los cambios fisiológicos que experimentaban aquellos que veían los vídeos de ASMR y encontraron reducciones mayores en sus frecuencias cardiacas. También tuvieron aumentos significativos en las emociones positivas como la relajación.
https://www nationalgeographic com es/ciencia/tien e-asmr-beneficios-para-salud-mental 21880

https://www nationalgeographic com es/ ciencia/70-anos-pulmon-acero-asi-fuevida-polio-paul-alexander 21854
BENEFICIOS DE HACER EJERCI

EL TESTIMONIO DE ‘POLIO PAUL’’
La vida de 'Polio Paul' Alexander es un testimonio conmovedor de la lucha contra la polio, una enfermedad viral que puede causar parálisis y afectar la respiración Contrajo la polio a los 6 años, lo que lo llevó a pasar la mayor parte de su vida dentro de un pulmón de acero para poder respirar. Su historia destaca la importancia de las vacunas para prevenir enfermedades como la polio, que, aunque ha sido eliminada en gran parte del mundo gracias a las vacunaciones, aún representa un riesgo en algunas áreas La valentía y la determinación de Paul inspiran a otros a enfrentar los desafíos con coraje y perseverancia.
https://im
Realizar ejercicio en ayunas puede ofrecer ventajas para mejorar la salud metabólica y la flexibilidad metabólica Esta práctica puede ayudar a movilizar las reservas de grasa y promover la utilización de grasas como fuente de energía durante el ejercicio, lo que puede ser beneficioso para aquellos con problemas metabólicos Además, el ejercicio en ayunas puede ayudar a mejorar la sensibilidad a la insulina y reducir los niveles de inflamación sistémica y postprandial Sin embargo, esta práctica debe ser realizada con precaución y bajo supervisión médica, especialmente por personas con problemas de salud subyacentes como diabetes, hipoglucemia o hipertensión
https://www.nationalgeographic.com.es/ciencia/3beneficios-hacer-ejercicio-ayunas 21763

08
ages app .goo.gl/p CbZV5D 9YiBFtse 67

EL ‘DÉJÀ VU’
El déjà vu, esa sensación de haber experimentado algo antes, aunque sea completamente nuevo, es un fenómeno intrigante que ha sido objeto de investigación en la neurociencia y la psicología Este fenómeno es común y se ha observado en personas de diferentes edades, aunque tiende a disminuir con el tiempo Se han identificado tres tipos diferentes de déjà vu: déjà visité, déjà vécu, y déjà senti. Además, existe un fenómeno inverso conocido como jamais vu, donde algo familiar se percibe como extraño o nuevo Aunque se han propuesto diversas teorías para explicar el déjà vu, como la desincronización neuronal, la memoria fragmentada, los errores de reconocimiento y otras, sigue siendo un misterio para la ciencia y una fascinante peculiaridad del cerebro humano
https://www nationalgeographic com es/ciencia/laciencia-detras-de-deja-vu-uno-de-los-grandesmisterios-cerebro 21743
NUEVA INFECCIÓN BACTERIANA
Una infección bacteriana causada por Streptococcus pyogenes está provocando preocupación en Japón, con un aumento de casos de síndrome de choque tóxico estreptocócico (STSS) Las bacterias estreptocócicas del grupo A son altamente contagiosas y se transmiten principalmente a través de gotitas respiratorias y contacto directo, aunque también pueden propagarse por alimentos contaminados Las enfermedades asociadas con el estreptococo A van desde la faringitis estreptocócica hasta el síndrome de choque tóxico estreptocócico, con síntomas que van desde fiebre y dolor de garganta hasta complicaciones graves que pueden ser mortales, especialmente en adultos mayores Aunque el brote parece estar limitado a Japón por el momento, las autoridades sanitarias deben estar atentas a cualquier desarrollo futuro
https://www.nationalgeographic.com.es/ciencia/alerta-porestreptococo-japon-que-es-como-se-contagia-y-cuales-sonsus-sintomas 21887#google vignette

09
BIOLOGICAL NEWSLETTER
En conclusión, los avances en la medicina y la ciencia están transformando nuestra comprensión y tratamiento de diversas enfermedades y fenómenos Desde la creación de miniórganos humanos utilizando células fetales del líquido amniótico hasta el descubrimiento de nuevas lesiones cerebrales mediante inteligencia artificial, pasando por la influencia hormonal en el cerebro durante el ciclo menstrual y los efectos del alcohol en la química cerebral, cada descubrimiento nos acerca a una mejor comprensión de la salud humana Sin embargo, también enfrentamos desafíos, como la aparición de nuevas enfermedades, como el brote de Streptococcus pyogenes en Japón, y la persistencia de enfermedades crónicas como la esclerosis lateral amiotrófica y el cáncer de mama. En este contexto, es esencial seguir avanzando en la investigación médica y científica para mejorar la prevención, detección y tratamiento de estas enfermedades, con el objetivo final de promover la salud y el bienestar de todas las personas


EL
CAMBIAR


10
MINIÓRGANOS
CICLO MENSTRUAL PUEDE
TU CEREBRO
ELA EL ‘DÉJÀ VU’
LA